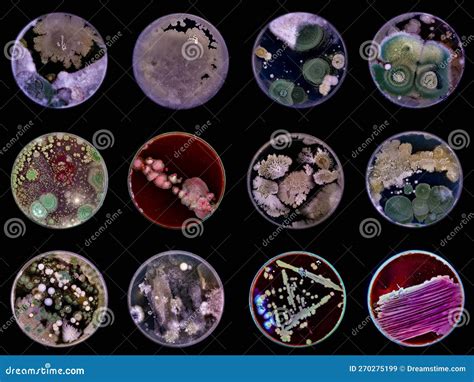
Cultivos de bacterias y hongos en placas de Petri

El aislamiento y la caracterización de microorganismos son pasos fundamentales en diversas áreas de la microbiología, desde la investigación hasta la producción industrial. El requisito primordial para llevar a cabo la identificación y caracterización de un microorganismo es disponer de un cultivo puro.
Las técnicas de cultivo e identificación de microorganismos son métodos ampliamente utilizados en el área microbiológica. Estos métodos conllevan el empleo de diversas técnicas de siembra, aislamiento y tinción con el fin de analizar las características morfológicas del microorganismo que se desea estudiar.
Si existe cualquier duda sobre la pureza del material recibido, el personal especializado contactará con el solicitante para determinar los pasos a seguir antes de proceder al aislamiento de los diferentes morfotipos presentes en el cultivo. El proceso de aislamiento, en ocasiones, tiene un coste adicional.
También se acepta ADN, acompañado de una imagen de un gel donde se observe su integridad, como material de partida para ciertos análisis.
Aplicaciones en la Industria Alimentaria: El Caso de las Levaduras en la Vinificación
En el ámbito de la ciencia de los alimentos, el aislamiento y la selección de microorganismos, como las levaduras, juegan un papel crucial. Un ejemplo destacado es el estudio de levaduras nativas en la producción de vinos, como en el caso de los viñedos de Querétaro, México.
Querétaro es el segundo estado productor de vinos en México, pero la comercialización enfrenta dificultades debido a la falta de calidad y tipicidad. Una alternativa para mejorar la calidad y originalidad de los vinos es la utilización de levaduras nativas seleccionadas.
El objetivo de estudios como este es el aislamiento, selección con base en su potencial enológico e identificación de levaduras nativas. Las cepas se aíslan durante la fermentación espontánea de mostos de uvas maduras, diferenciando las levaduras del género *Saccharomyces* en medios selectivos como el medio lisina.
Entre las levaduras seleccionadas, algunas destacan por su tolerancia a SO2, etanol y por presentar el fenotipo killer. Las cepas de *Saccharomyces cerevisiae* y *Saccharomyces paradoxus* han mostrado resultados prometedores.
Los vinos producidos con estas levaduras nativas presentan características deseables, como un bajo contenido de azúcares residuales y una acidez adecuada. Algunas cepas nativas, junto con cepas de referencia, han obtenido altos grados alcohólicos y eficiencias fermentativas notables.
El comportamiento fermentativo de las levaduras se evalúa mediante diversas variables, como el grado alcohólico, la eficiencia fermentativa, la conversión azúcar/etanol y la velocidad de fermentación. Además, se analizan parámetros físico-químicos del vino, como azúcares reductores, pH, acidez total y volátil, y contenido de SO2.
La identificación de las levaduras seleccionadas se realiza mediante técnicas moleculares, como la amplificación del dominio D1/D2 del gen que codifica para la subunidad 26S del ARNr, seguida de secuenciación de ADN.
Este tipo de estudios revela el potencial de las levaduras nativas de una región para ser utilizadas en la producción de bebidas fermentadas, mejorando la calidad y aportando características únicas a los productos regionales.

Aislamiento y Caracterización de Microorganismos en Otros Contextos
Las técnicas de aislamiento y caracterización no se limitan a la producción de vino. Por ejemplo, se han aplicado al estudio de microorganismos presentes en el consorcio de la kombucha, una bebida fermentada azucarada.
En estos estudios, se replica e incrementa la concentración de los microorganismos presentes en la kombucha. Se utilizan medios específicos para el aislamiento de bacterias y levaduras, seguido de una caracterización morfológica diferencial y bioquímica para confirmar los tipos de microorganismos.
Los aislados son sometidos a caracterización molecular. Correlacionando los criterios morfológicos, bioquímicos y moleculares, se pueden identificar organismos pertenecientes a familias específicas, como *Acetobacteraceae*, y levaduras de géneros como *Zygosaccharomyces*, que son prevalentes en el consorcio de kombucha.
Otras especies bacterianas, como *Bacillus sp.*, *Bacillus amyloliquefaciens* y *Stenotrophomonas maltophilia*, así como levaduras como *Meyerozyma guilliermondii*, también pueden ser identificadas, aunque sean menos prevalentes pero reportadas en otras fermentaciones.
Un ejemplo de análisis morfológico aplicado al estudio de hongos es el análisis de una muestra de hongo obtenida a partir de Limón Persa (*Citrus latifolia* Tan). Entre las técnicas utilizadas se encuentran la técnica de Ridell o Microcultivo, Zymogram y Cuantificación por Recuento en Placa.
Se realizaron tinciones simples, utilizando el colorante Azul de Lactofenol, para finalmente analizar las muestras por microscopía de Campo Claro. Los resultados obtenidos pueden revelar la presencia de diversas estructuras morfológicas, como conidióforos pertenecientes al género *A. niger*, presencia de artrosporas de la levadura *G. citri-aurantii*, y esporas como *P. digitatum*, las cuales son corroboradas por otros análisis y bibliografía.
Métodos y Técnicas Clave en el Aislamiento y Caracterización
El requisito fundamental para llevar a cabo la identificación y caracterización es disponer de un cultivo puro del microorganismo. Si existe cualquier duda sobre la pureza del material recibido, el personal especializado contactará con el solicitante para determinar los pasos a seguir antes de proceder al aislamiento de los diferentes morfotipos presentes en el cultivo.
Las técnicas de cultivo e identificación de microorganismos son métodos ampliamente utilizados en el área microbiológica, conllevan el empleo de diversos métodos de siembra, aislamiento y tinción con el fin de analizar las características morfológicas del microorganismo que se desea estudiar.
La diferenciación de cepas, como las del género *Saccharomyces*, puede realizarse en medios selectivos. La evaluación de la tolerancia a compuestos como el etanol o el SO2 se lleva a cabo inoculando las levaduras en medios específicos y monitorizando su viabilidad y cinética de crecimiento.
La tolerancia al fenotipo killer se evalúa mediante la obtención de caldo-toxina de cepas de referencia y su aplicación a las cepas aisladas, observando el porcentaje de inhibición del crecimiento.
Las pruebas de microvinificación implican la inoculación de mostos con cepas seleccionadas y la fermentación controlada. Durante este proceso, se determinan variables como el grado alcohólico, la eficiencia fermentativa, la conversión azúcar/etanol y la velocidad de fermentación.
La identificación molecular, mediante PCR y secuenciación de ADN, es una herramienta poderosa para confirmar la identidad de los microorganismos aislados, complementando la información obtenida por métodos morfológicos y bioquímicos.
AISLAMIENTO DE MICROORGANISMOS
Tabla 1: Parámetros evaluados en la fermentación de vinos con levaduras nativas
| Parámetro | Método de Determinación | Unidades |
|---|---|---|
| Grado alcohólico | Destilación directa y picnometría | % |
| Eficiencia fermentativa | Cálculo basado en alcohol producido y potencial | % |
| Conversión azúcar/etanol | Cálculo | g de azúcar / ° alcohólico |
| Velocidad de fermentación | Medición de CO2 desprendido | g CO2 / 48 h |
| Azúcares reductores | Método de Fehling Causse Bonnans | g L-1 |
| pH | Potenciómetro | Unidades de pH |
| Acidez total titulable (ATT) | Titulación | g L-1 ácido tartárico |
| Acidez volátil (AV) | Método de García-Tena | g L-1 ácido acético |
| SO2 total | Método de Rippert | mg L-1 |
tags: #aislamiento #y #caracterizacion #de #bacterias #hongos